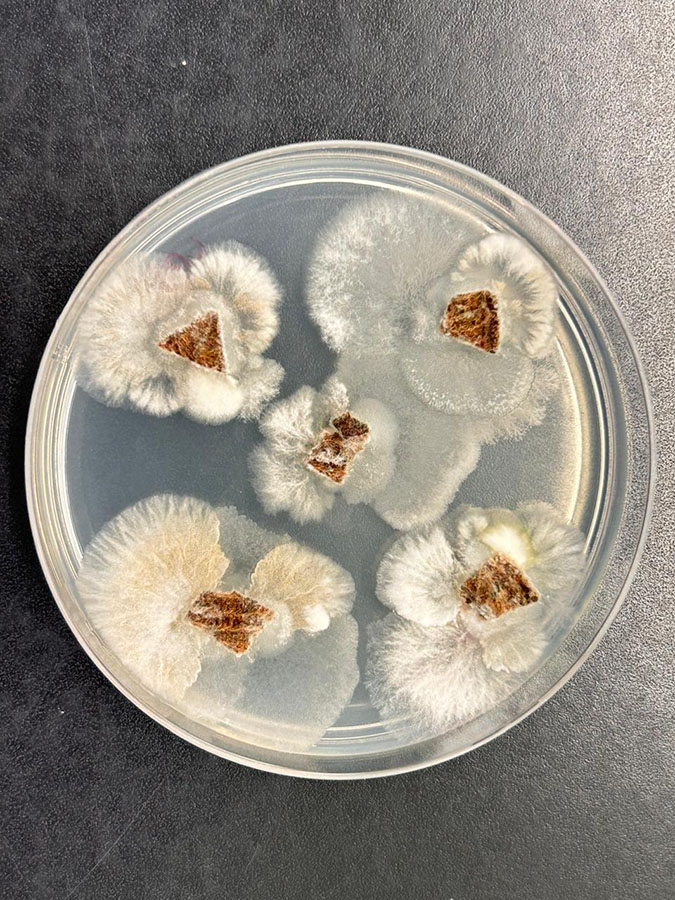

- Fungo endofítico, microrganismo que vive dentro de tecidos vegetais, isolado de uma planta tropical, produziu substâncias bioativas com potencial herbicida e antifúngico.
- Entre esses metabólitos, o batizado como composto “2” foi descrito pela primeira vez e mostrou desempenho superior ao de alguns pesticidas sintéticos.
- Ensaios comparativos revelaram que o composto mostra ação mais potente que a de herbicidas como glifosato e clomazona.
- A pesquisa reforça a biodiversidade brasileira como fonte de moléculas inovadoras para bioinsumos destinados ao uso na agricultura.
- Os próximos passos incluem estudos de segurança, mecanismos de ação e formulação de produtos comerciais..
A partir do isolamento de um fungo endofítico, microrganismos que vive nos tecidos vegetais, encontrado em uma planta medicinal tropical do gênero Piper, uma equipe formada por cientistas da Universidade Federal de Minas Gerais (UFMG), do United States Department of Agricuture ( USDA – Departamento de Agricultura dos Estados Unidos, em português) e da Embrapa Meio Ambiente (SP) identificou substâncias com potencial herbicida e antifúngico. Entre elas, uma inédita na literatura científica — batizada pelos cientistas como composto “2” (5,10-di-hidroxi-1,7-dimetoxi-3-metil-1H-benzo[g]isocromeno-6,9-diona) — que apresentou desempenho comparável ou superior a alguns pesticidas sintéticos já comercializados.
O estudo representa o primeiro registro da atividade biológica dessa substância, ampliando o leque de moléculas naturais que podem ser exploradas para o desenvolvimento de defensivos agrícolas alternativos aos pesticidas sintéticos. “Esses microrganismos endofíticos são um reservatório promissor e ainda pouco explorado de metabólitos bioativos, capazes de gerar soluções inovadoras para a agricultura”, avalia o professor da UFMG Luiz Henrique Rosa.
Microrganismos aliados invisíveis
Fungos endofíticos vivem no interior de tecidos vegetais durante parte ou todo o ciclo de vida da planta e sem causar sintomas aparentes de doença. Pelo contrário: em muitos casos, estabelecem uma relação de simbiose harmônica, em que ambos os organismos saem ganhando. Enquanto o fungo encontra proteção e nutrientes, a planta recebe substâncias químicas que podem fortalecê-la contra herbívoros e patógenos.
“Essa capacidade de produzir metabólitos variados já despertava o interesse científico há algumas décadas”, afirma Rosa. “No entanto, o ritmo das descobertas tem se intensificado com a demanda por bioinsumos que substituam ou complementem pesticidas sintéticos. Além de reduzir impactos ambientais e riscos à saúde humana, os defensivos de origem biológica podem enfrentar um dos maiores problemas atuais do campo: a resistência crescente de pragas e doenças a produtos químicos sintéticos convencionais”, destaca o professor.
Sobre o fungo isolado

Entre os microrganismos endófitos isolados, destacou-se um fungo identificado como Fusarium sp. UFMGCB 15449. O gênero Fusarium, pertencente à família Nectriaceae, é um dos mais presentes no planeta, com mais de 70 espécies descritas. Amplamente encontrado no solo, em plantas e em substratos orgânicos, o grupo é conhecido tanto por sua capacidade de causar doenças em culturas agrícolas quanto por produzir substâncias de interesse biotecnológico.
De acordo com a pesquisadora da UFMG Debora Barreto, algumas espécies de Fusarium são reconhecidas como importantes produtoras de micotoxinas, capazes de interferir no sistema imunológico de plantas e animais. Ao mesmo tempo, pesquisas anteriores já haviam registrado a ação antimicrobiana de endófitos desse gênero em cafeeiros e em espécies medicinais como Dioscorea zingiberensis. “O estudo conduzido pela equipe da UFMG, da Embrapa Meio Ambiente e do Departamento de Agricultura dos Estados Unidos aprofunda essa linha de investigação, revelando novas possibilidades de uso”, acredita ela.
O fungo estudado foi coletado no Parque Estadual da Floresta do Rio Doce (MG), em julho de 2017, e armazenado na Coleção de Micro-Organismos e Células da UFMG. A identificação envolveu técnicas avançadas de biologia molecular, incluindo análise de sequências de DNA e comparação com dados depositados no GenBank, banco de dados que permite o acesso da comunidade científica às informações mais atualizadas e abrangentes sobre sequências de DNA.
Apesar da confirmação do gênero Fusarium, os cientistas não conseguiram determinar a espécie com precisão, devido às complexidades taxonômicas do grupo. Isso não é incomum, já que Fusarium apresenta registros variáveis e inconsistentes ao longo da literatura científica. Ainda assim, a caracterização morfológica e genética foi suficiente para avançar nos testes com os metabólitos produzidos.
Substâncias metabólicas encontradas e o potencial do “composto 2”
O extrato do fungo foi submetido em um bioensaio em sementes de alface (Lactuca sativa) e grama-de-bent (Agrostis stolonifera), modelos vegetais comuns em estudos de herbicidas. Três metabólitos foram isolados: anidrofusarubina (potencial antimicrobiano e antibacteriano), javanicina (atividade antimicrobiana) e o composto “2”.
Em concentrações de 1 mg/mL, todos os compostos mostraram atividade fitotóxica (adversa ao desenvolvimento das plantas) significativa, inibindo totalmente a germinação das sementes de plantas daninhas indesejadas — efeito comparável ao herbicida sintético acifluorfeno na mesma dosagem. Ensaios adicionais com lentilha-d’água (Lemna), espécie frequentemente usada pela indústria de pesticidas para medir toxicidade, confirmaram o potencial. Os compostos apresentaram valores de IC50 (concentração necessária para reduzir o crescimento em 50%) bem inferiores aos de herbicidas amplamente utilizados, como glifosato e clomazona.
Para a pesquisadorada Embrapa Meio Ambiente Sonia Queiroz, em relação à atividade antifúngica, os testes contra o patógeno agrícola Colletotrichum fragariae também foram animadores. O metabólito “2” destacou-se com zonas de inibição mais amplas do que as de fungicidas naturais usados como referência, como o carvacrol e o timol. Os outros metabólitos, embora menos expressivos, também demonstraram atividade, indicando que há espaço para otimizações químicas.

Alternativas para a agricultura global
Os pesticidas sintéticos vêm sendo utilizados desde a década de 1940 para proteger lavouras contra ervas daninhas, insetos e fungos. Como resultado, houve um aumento da produtividade agrícola, mas também o surgimento de problemas ambientais, intoxicações humanas e desequilíbrios ecológicos.
Atualmente, o setor agrícola enfrenta um dilema: manter a produção suficiente para alimentar quase 10 bilhões de pessoas até 2050, mas com menos impacto ambiental e maior eficiência no uso de recursos. “Nesse cenário, bioinsumos como os metabólitos de fungos endofíticos aparecem como alternativas promissoras, capazes de unir eficácia no campo e sustentabilidade, afirma Sonia Queiroz.”
O estudo reforça a importância da biodiversidade brasileira como um dos maiores patrimônios científicos do planeta. Florestas tropicais, cerrados e outros biomas abrigam microrganismos ainda pouco explorados, que podem gerar inovações em saúde, agricultura e indústria.
“No caso do Fusarium, endofítico isolado em Minas Gerais, o trabalho marca o início de um processo que pode culminar em novos herbicidas e fungicidas comerciais”, acredita o professor Luiz Henrique Rosa.
Para isso, os pesquisadores destacam que são necessárias etapas adicionais: estudos sobre os alvos moleculares dos metabólitos, análises de segurança ambiental e toxicológica, além da possibilidade de modificar estruturalmente as moléculas para aumentar sua eficácia.
Fronteira científica
Os resultados iniciais abrem caminho para pesquisas mais aplicadas, incluindo a avaliação do desempenho dos compostos em condições de campo e sua integração em formulações comerciais. Também há interesse em explorar o fenômeno de hormese observado nos testes, em que doses baixas estimularam o crescimento vegetal, indicando potencial para usos diferenciados.
“Estamos diante de uma fronteira científica em que microrganismos invisíveis podem se transformar em aliados estratégicos da agricultura”, concluem os autores.
Trabalho publicado
Artigo sobre o trabalho de pesquisa pode ser acessado aqui. A autoria é de Debora Barreto da Universidade Federal de Minas Gerais (UFMG); Charles Cantrell, Seong Kim, Joanna Bajsa-Hirsche, Prabin Tamang e Stephen Duke do United States Department of Agriculture, Agricultural Research Service, Natural Products Utilization Research Unit; Camila de Carvalho da UFMG; Sonia Queiroz da Embrapa Meio Ambiente; e Luiz Henrique Rosa da UFMG.
Fonte: Cristina Tordin – Embrapa Meio Ambiente




